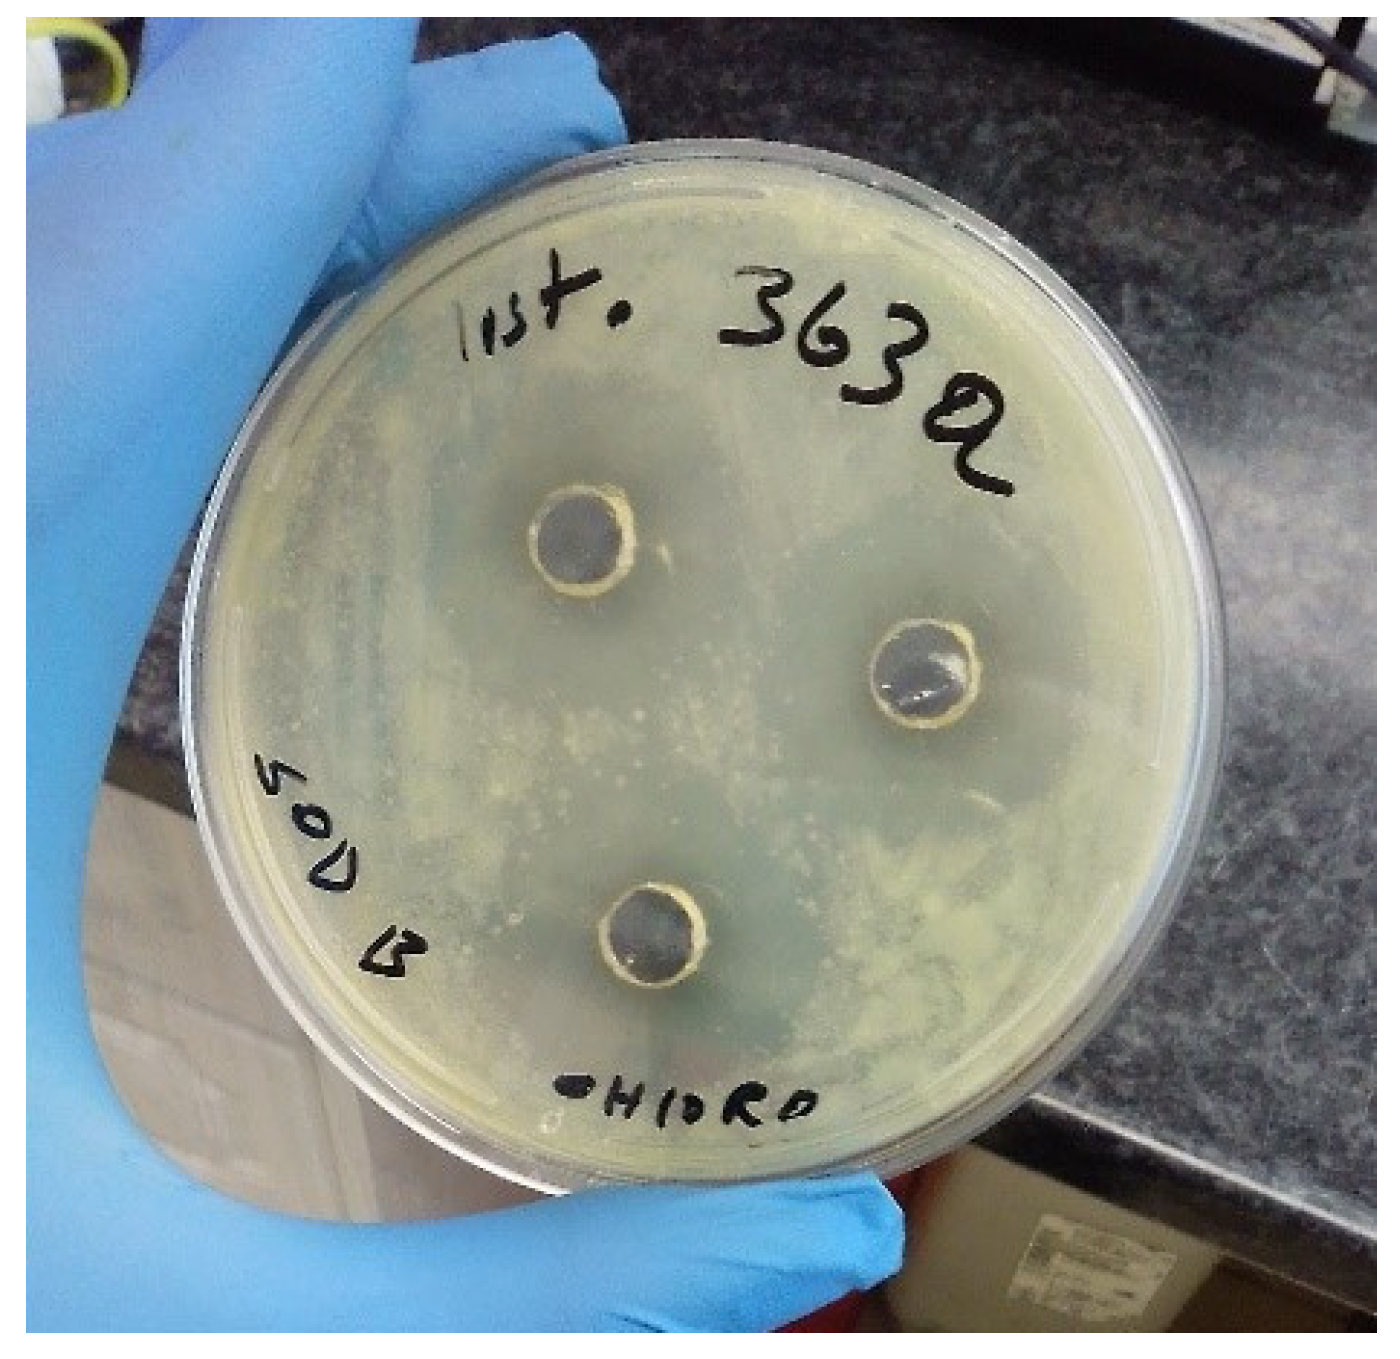
Microorganisms 11 02539 g003

Evaluation of Antimicrobial Activity by Marine Nocardiopsis dassonvillei against Foodborne Listeria monocytogenes and Shiga Toxin-Producing Escherichia coli
Abstract
:1. Introduction
2. Materials and Methods
2.1. Media Formulations
2.1.1. Cross-Streak Agar
2.1.2. Fermentation Broth
2.2. Test Bacteria
2.3. Sample Collection
2.4. Physicochemical Parameters of the Seawater
2.5. Sample Preparation
2.6. Isolation of Actinomycetes
2.7. The Screening for Antibacterial Compounds Production in Actinomycetes
2.7.1. Primary Screening of Antibacterial Activity
2.7.2. Secondary Screening for Antibacterial Activity of Actinomycete Isolates
2.8. Identification of Actinomycetes
2.9. Phylogenetic Analysis
2.10. Extraction of the Secondary Metabolites
2.11. Chemical Composition Analysis of the N. dassonvillei SOD(B)ST2SA2′s Extract
2.12. Antibacterial Assay of the Chloroform Extract
2.12.1. Minimum Inhibitory Concentration (MIC) of the Extract
2.12.2. Minimum Bactericidal Concentration (MBC)
2.12.3. Mechanism of Antibacterial Activity of the Extract
3. Results
3.1. Physicochemical Parameters of the Marine Water
3.2. Isolation and Identification of Actinomycetes
3.3. Screening of Antibacterial Activity of Actinomycetes
3.4. Molecular Identification and Phylogenetic Analysis
3.5. Extraction of the Secondary Metabolites
3.6. Chemical Composition Analysis of the Chloroform Extract of N. dassonvillei SOD(B)ST2SA2
3.7. Antibacterial Activity of the Crude Extracts of N. dassonvillei SOD(B)ST2SA2
3.7.1. Agar-Well Diffusion Method
3.7.2. MIC and MBC of the Chloroform Extract
3.8. Antibacterial Activity Mechanism
3.8.1. Binding Scores of the Docked Complexes
3.8.2. Molecular Interactions
4. Discussion
5. Conclusions
Supplementary Materials
Author Contributions
Funding
Institutional Review Board Statement
Data Availability Statement
Acknowledgments
Conflicts of Interest
References
- Karama, M.; Cenci-Goga, B.T.; Malahlela, M.; Smith, A.M.; Keddy, K.H.; El-Ashram, S.; Kabiru, L.M.; Kalake, A. Virulence characteristics and antimicrobial resistance profiles of Shiga toxin-producing Escherichia coli isolates from humans in South Africa: 2006–2013. Toxins 2019, 11, 424. [Google Scholar] [CrossRef] [PubMed]
- Uludag, A.A.; Aydogdu, E.Ö.A.; Kimiran, A. The determination of presence of Listeria monocytogenes in ground meat sold in Istanbul. GU J. Sci. 2023, 36, 53–66. [Google Scholar] [CrossRef]
- Moreno, L.Z.; Paixão, R.; Gobbi, D.D.; Raimundo, D.C.; Ferreira, T.P.; Moreno, A.M.; Hofer, E.; Reis, C.M.; Matté, G.R.; Matté, M.H. Characterization of antibiotic resistance in Listeria spp. isolated from slaughterhouse environments, pork and human infections. J. Infect. Dev. Ctries. 2014, 8, 416–423. [Google Scholar] [CrossRef] [PubMed]
- Charpentier, E.; Courvalin, P. Antibiotic resistance in Listeria spp. Antimicrob. Agents Chemother. 1999, 43, 2103–2108. [Google Scholar] [CrossRef]
- World Health Organization. Available online: https://www.who.int/news-room/fact-sheets/detail/antimicrobial-resistance (accessed on 10 July 2023).
- Hamed, A.A.; Mohamed, O.G.; Aboutabl, E.A.; Fathy, F.I.; Fawzy, G.A.; El-Shiekh, R.A.; Al-Karmalawy, A.A.; Al-Taweel, A.M.; Tripathi, A.; Elsayed, T.R. Identification of antimicrobial metabolites from the Egyptian soil-derived Amycolatopsis keratiniphila revealed by untargeted metabolomics and molecular docking. Metabolites 2023, 13, 620. [Google Scholar] [CrossRef]
- Mota, M.I.; Vázquez, S.; Cornejo, C.; D’Alessandro, B.; Braga, V.; Caetano, A.; Betancor, L.; Varela, G. Does Shiga toxin-producing Escherichia coli and Listeria monocytogenes contribute significantly to the burden of antimicrobial resistance in Uruguay? Front. Vet. Sci. 2020, 7, 583930. [Google Scholar] [CrossRef]
- Gómez, D.; Azón, E.; Marco, N.; Carramiñana, J.J.; Rota, C.; Ariño, A.; Yangüela, J. Antimicrobial resistance of Listeria monocytogenes and Listeria innocua from meat products and meat-processing environment. Food Microbiol. 2014, 42, 61–65. [Google Scholar] [CrossRef]
- Matle, I.; Mbatha, K.R.; Lentsoane, O.; Magwedere, K.; Morey, L.; Madoroba, E. Occurrence, serotypes, and characteristics of Listeria monocytogenes in meat and meat products in South Africa between 2014 and 2016. J. Food Saf. 2019, 39, e12629. [Google Scholar] [CrossRef]
- de Noordhout, C.M.; Devleesschauwer, B.; Angulo, F.J.; Verbeke, G.; Haagsma, J.; Kirk, M.; Havelaar, A.; Speybroeck, N. The global burden of listeriosis: A systematic review and meta-analysis. Lancet Infect. Dis. 2014, 14, 1073–1082. [Google Scholar] [CrossRef]
- Dufailu, O.A.; Yaqub, M.O.; Owusu-Kwarteng, J.; Addy, F. Prevalence and characteristics of Listeria species from selected African countries. Trop. Dis. Travel Med. Vaccines 2021, 7, 26. [Google Scholar] [CrossRef] [PubMed]
- Al-Brefkani, A.M.T. Study the antimicrobial resistance genes of Listeria monocytogenes isolated from industrial and clinical samples in Iraq. Iraqi J. Sci. 2023, 64, 594–604. [Google Scholar] [CrossRef]
- Vishnuraj, M.; Ajay, G.; Aravind Kumar, N.; Renuka, J.; Pollumahanti, N.; Anusha Chauhan, H.; Vaithiyanathan, S.; Rawool, D.B.; Barbuddhe, S. Duplex real-time PCR assay with high-resolution melt analysis for the detection and quantification of Listeria species and Listeria monocytogenes in meat products. J. Food Sci. Technol. 2023, 60, 1541–1550. [Google Scholar] [CrossRef] [PubMed]
- Walsh, D.; Duffy, G.; Sheridan, J.; Blair, I.; McDowell, D. Antibiotic resistance among Listeria, including Listeria monocytogenes, in retail foods. J. Appl. Microbiol. 2001, 90, 517–522. [Google Scholar] [CrossRef] [PubMed]
- Da Rocha, L.S.; Gunathilaka, G.U.; Zhang, Y. Antimicrobial-resistant Listeria species from retail meat in metro Detroit. J. Food Prot. 2012, 75, 2136–2141. [Google Scholar] [CrossRef] [PubMed]
- Matle, I.; Mbatha, K.R.; Madoroba, E. A review of Listeria monocytogenes from meat and meat products: Epidemiology, virulence factors, antimicrobial resistance and diagnosis. Onderstepoort J. Vet. Res. 2020, 87, 1–20. [Google Scholar] [CrossRef] [PubMed]
- Luque-Sastre, L.; Arroyo, C.; Fox, E.M.; McMahon, B.J.; Bai, L.; Li, F.; Fanning, S. Antimicrobial resistance in Listeria species. Microbiol. Spectr. 2018, 6, 237–259. [Google Scholar] [CrossRef] [PubMed]
- Kayode, A.J.; Igbinosa, E.O.; Okoh, A.I. Overview of listeriosis in the Southern African Hemisphere. J. Food Saf. 2020, 40, e12732. [Google Scholar] [CrossRef]
- Iweriebor, B.C.; Iwu, C.J.; Obi, L.C.; Nwodo, U.U.; Okoh, A.I. Multiple antibiotic resistances among Shiga toxin-producing Escherichia coli O157 in feces of dairy cattle farms in Eastern Cape of South Africa. BMC Microbiol. 2015, 15, 213. [Google Scholar] [CrossRef] [PubMed]
- Canpolat, N. Hemolytic uremic syndrome. Turk. Pediatri. Ars. 2015, 50, 73–82. [Google Scholar] [CrossRef] [PubMed]
- Majowicz, S.E.; Scallan, E.; Jones-Bitton, A.; Sargeant, J.M.; Stapleton, J.; Angulo, F.J.; Yeung, D.H.; Kirk, M.D. Global incidence of human Shiga toxin–producing Escherichia coli infections and deaths: A systematic review and knowledge synthesis. Foodborne Pathog. Dis 2014, 11, 447–455. [Google Scholar] [CrossRef]
- Onyeka, L.O.; Adesiyun, A.A.; Keddy, K.H.; Manqele, A.; Madoroba, E.; Thompson, P.N. Prevalence and patterns of fecal shedding of Shiga toxin–producing Escherichia coli by cattle at a commercial feedlot in South Africa. J. Food Saf. 2022, 42, e12961. [Google Scholar] [CrossRef]
- Varcasia, B.M.; Tomassetti, F.; De Santis, L.; Di Giamberardino, F.; Lovari, S.; Bilei, S.; De Santis, P. Presence of Shiga toxin-producing Escherichia coli (STEC) in fresh beef marketed in 13 regions of Italy (2017). Microorganisms 2018, 6, 126. [Google Scholar] [CrossRef]
- Onyeka, L.O.; Adesiyun, A.A.; Keddy, K.H.; Madoroba, E.; Manqele, A.; Thompson, P.N. Shiga toxin–producing Escherichia coli contamination of raw beef and beef-based ready-to-eat products at retail outlets in Pretoria, South Africa. J. Food Prot. 2020, 83, 476–484. [Google Scholar] [CrossRef] [PubMed]
- Berhilevych, O.; Kasianchuk, V.; Deriabin, O.; Kukhtyn, M. Isolation of Shiga toxin-producing strains of Escherichia coli from beef and swine carcasses and the characterization of their genes. Regul. Mech. Biosyst. 2018, 9, 275–280. [Google Scholar] [CrossRef]
- Agger, M.; Scheutz, F.; Villumsen, S.; Mølbak, K.; Petersen, A.M. Antibiotic treatment of verocytotoxin-producing Escherichia coli (VTEC) infection: A systematic review and a proposal. J. Antimicrob. Chemother. 2015, 70, 2440–2446. [Google Scholar] [CrossRef] [PubMed]
- de Kraker, M.E.; Lipsitch, M. Burden of antimicrobial resistance: Compared to what? Epidemiol. Rev. 2021, 43, 53–64. [Google Scholar] [CrossRef] [PubMed]
- Norouzi, H.; Danesh, A.; Mohseni, M.; Khorasgani, M.R. Marine actinomycetes with probiotic potential and bioactivity against multidrug-resistant bacteria. Int. J. Mol. Cell. Med. 2018, 7, 44–52. [Google Scholar]
- Selim, M.S.M.; Abdelhamid, S.A.; Mohamed, S.S. Secondary metabolites and biodiversity of actinomycetes. J. Genet. Eng. Biotechnol. 2021, 19, 72. [Google Scholar] [CrossRef]
- Jose, P.A.; Jebakumar, S.R.D. Non-streptomycete actinomycetes nourish the current microbial antibiotic drug discovery. Front. Microbiol. 2013, 4, 240. [Google Scholar] [CrossRef] [PubMed]
- Jagannathan, S.V.; Manemann, E.M.; Rowe, S.E.; Callender, M.C.; Soto, W. Marine actinomycetes, new sources of biotechnological products. Mar. Drugs 2021, 19, 365. [Google Scholar] [CrossRef] [PubMed]
- Dhakal, D.; Pokhrel, A.R.; Shrestha, B.; Sohng, J.K. Marine rare actinobacteria: Isolation, characterization, and strategies for harnessing bioactive compounds. Front. Microbiol. 2017, 8, 1106. [Google Scholar] [CrossRef]
- Siddharth, S.; Rai, V.R. Isolation and characterization of bioactive compounds with antibacterial, antioxidant and enzyme inhibitory activities from marine-derived rare actinobacteria, Nocardiopsis sp. SCA21. Microb. Pathog. 2019, 137, 103775. [Google Scholar] [CrossRef] [PubMed]
- Passari, A.K.; Mishra, V.K.; Singh, G.; Singh, P.; Kumar, B.; Gupta, V.K.; Sarma, R.K.; Saikia, R.; Donovan, A.O.; Singh, B.P. Insights into the functionality of endophytic actinobacteria with a focus on their biosynthetic potential and secondary metabolites production. Sci. Rep. 2017, 7, 11809. [Google Scholar] [CrossRef] [PubMed]
- Bennur, T.; Kumar, A.; Zinjarde, S.; Javdekar, V. Nocardiopsis species as potential sources of diverse and novel extracellular enzymes. Appl. Microbiol. Biotechnol. 2014, 98, 9173–9185. [Google Scholar] [CrossRef] [PubMed]
- Kroppenstedt, R.M.; Evtushenko, L.I. The family Nocardiopsaceae. In The Prokaryotes: A Handbook on the Biology of Bacteria; Dworkin, M., Falkow, S., Rosenberg, E., Schleifer, K.H., Eds.; Springer: New York, NY, USA, 2006; pp. 754–795. [Google Scholar]
- Bennur, T.; Kumar, A.R.; Zinjarde, S.; Javdekar, V. Nocardiopsis species: Incidence, ecological roles and adaptations. Microbiol. Res. 2015, 174, 33–47. [Google Scholar] [CrossRef] [PubMed]
- Srinivasan, R.; Kannappan, A.; Shi, C.; Lin, X. Marine bacterial secondary metabolites: A treasure house for structurally unique and effective antimicrobial compounds. Mar. Drugs 2021, 19, 530. [Google Scholar] [CrossRef]
- Romano, G.; Costantini, M.; Sansone, C.; Lauritano, C.; Ruocco, N.; Ianora, A. Marine microorganisms as a promising and sustainable source of bioactive molecules. Mar. Environ. Res. 2017, 128, 58–69. [Google Scholar] [CrossRef]
- Takizawa, M.; Colwell, R.R.; Hill, R.T. Isolation and diversity of actinomycetes in the Chesapeake Bay. Appl. Environ. Microbiol. 1993, 59, 997–1002. [Google Scholar] [CrossRef] [PubMed]
- Subramani, R.; Sipkema, D. Marine rare actinomycetes: A promising source of structurally diverse and unique novel natural products. Mar. Drugs 2019, 17, 249. [Google Scholar] [CrossRef]
- Valli, S.; Suvathi, S.S.; Aysha, O.S.; Nirmala, P.; Vinoth, K.P.; Reena, A. Antimicrobial potential of actinomycetes species isolated from marine environment. Asian Pac. J. Trop. Biomed. 2012, 2, 469–473. [Google Scholar] [CrossRef] [PubMed]
- Dudeja, S.; Chhokar, V.; Badgujjar, H.; Chauhan, R.; Soni, S.; Beniwal, V.; Kumar, A. Isolation and screening of antibiotic producing fungi from solid-state waste. Polymorphism 2020, 4, 59–71. [Google Scholar]
- Pandya, D.D.; Ram, D. Screening and characteristic study of antimicrobial actinomycetes from near-by soil of medicinal plants. Int. J. Pharm. Pharm. Sci. 2018, 10, 66–73. [Google Scholar] [CrossRef]
- Priyanka, S.; Jayashree, M.; Shivani, R.; Anwesha, S.; Rao, K.B. Characterisation and identification of antibacterial compound from marine actinobacteria: In vitro and in silico analysis. J. Infect. Public Health 2019, 12, 83–89. [Google Scholar] [CrossRef]
- Gharechahi, J.; Zahiri, H.S.; Noghabi, K.A.; Salekdeh, G.H. In-depth diversity analysis of the bacterial community resident in the camel rumen. Syst. Appl. Microbiol. 2015, 38, 67–76. [Google Scholar] [CrossRef] [PubMed]
- Shubha, M.; Ushashi, B.; Veena, S.; Bhaskara, R. Antimicrobial activity of Streptomyces variabilis strain-VITUMVB03 isolated from Kanyakumari marine sediments. Asian J. Pharm. Clin. Res. 2017, 10, 112–116. [Google Scholar]
- Ara, I.; Bukhari, N.A.; Aref, N.; Shinwari, M.M.; Bakir, M. Antiviral activities of streptomycetes against tobacco mosaic virus (TMV) in Datura plant: Evaluation of different organic compounds in their metabolites. Afr. J. Biotechnol. 2012, 11, 2130–2138. [Google Scholar]
- Eloff, J.N. A sensitive and quick microplate method to determine the minimal inhibitory concentration of plant extracts for bacteria. Planta Med. 1998, 64, 711–713. [Google Scholar] [CrossRef]
- Kamazeri, T.S.A.T.; Abd Samah, O.; Taher, M.; Susanti, D.; Qaralleh, H. Antimicrobial activity and essential oils of Curcuma aeruginosa, Curcuma mangga, and Zingiber cassumunar from Malaysia. Asian Pac. J. Trop. Med. 2012, 5, 202–209. [Google Scholar] [CrossRef] [PubMed]
- Nxumalo, C.I.; Ngidi, L.S.; Shandu, J.S.E.; Maliehe, T.S. Isolation of endophytic bacteria from the leaves of Anredera cordifolia CIX1 for metabolites and their biological activities. BMC Complement. Altern. Med. 2020, 20, 300. [Google Scholar] [CrossRef] [PubMed]
- Adejoro, I.A.; Babatunde, D.D.; Tolufashe, G.F. Molecular docking and dynamic simulations of some medicinal plants compounds against SARS-CoV-2: An in silico study. J. Taibah Univ. Sci. 2020, 14, 1563–1570. [Google Scholar] [CrossRef]
- Gupta, S.; Singh, A.K.; Kushwaha, P.P.; Prajapati, K.S.; Shuaib, M.; Senapati, S.; Kumar, S. Identification of potential natural inhibitors of SARS-CoV2 main protease by molecular docking and simulation studies. J. Biomol. Struct. Dyn. 2021, 39, 4334–4345. [Google Scholar] [CrossRef]
- Trott, O.; Olson, A.J. AutoDock Vina: Improving the speed and accuracy of docking with a new scoring function, efficient optimization, and multi-threading. J. Comput. Chem. 2010, 31, 455–461. [Google Scholar] [CrossRef] [PubMed]
- Basu, S.; Roychoudhury, U.; Das, M.; Datta, G. Identification of bioactive components in ethanolic and aqueous extracts of Amorphophallus campanulatus tuber by GC-MS analysis. Int. J. Phytomed. 2013, 5, 243. [Google Scholar]
- Gheda, S.; Khalil, M.; Gheida, S. In vitro and in vivo preliminary results on Spirulina platensis for treatment of impetigo: Topical cream application. Afr. J. Biotechnol. 2013, 12, 2498–2509. [Google Scholar]
- Ghalloo, B.A.; Khan, K.-u.-R.; Ahmad, S.; Aati, H.Y.; Al-Qahtani, J.H.; Ali, B.; Mukhtar, I.; Hussain, M.; Shahzad, M.N.; Ahmed, I. Phytochemical profiling, in vitro biological activities, and in silico molecular docking studies of Dracaena reflexa. Molecules 2022, 27, 913. [Google Scholar] [CrossRef]
- Ibrahim, H.; Osilesi, O.; Adebawo, O.; Onajobi, F.; Karigidi, K.; Muhammad, L. Nutrients compositions and phytochemical contents of edible parts of Chrysophyllum albidum fruit. J. Nutr. Food Sci. 2017, 7, 2. [Google Scholar]
- Tonisi, S.; Okaiyeto, K.; Mabinya, L.V.; Okoh, A.I. Evaluation of bioactive compounds, free radical scavenging and anticancer activities of bulb extracts of Boophone disticha from Eastern Cape Province, South Africa. Saudi J. Biol. Sci. 2020, 27, 3559–3569. [Google Scholar] [CrossRef]
- Ferdosi, M.; Ahmed, H.; Khan, I.; Javaid, A. Fungicidal potential of flower extract of Cassia fistula against Macrophomina phaseolina and Sclerotium rolfsii. J. Anim. Plant Sci. 2022, 32, 1028–1034. [Google Scholar]
- Ruiz-Torres, V.; Rodríguez-Pérez, C.; Herranz-López, M.; Martín-García, B.; Gómez-Caravaca, A.M.; Arráez-Román, D.; Segura-Carretero, A.; Barrajón-Catalán, E.; Micol, V. Marine invertebrate extracts induce colon cancer cell death via ROS-mediated DNA oxidative damage and mitochondrial impairment. Biomolecules 2019, 9, 771–808. [Google Scholar] [CrossRef]
- Selvin, J.; Shanmughapriya, S.; Gandhimathi, R.; Seghal Kiran, G.; Rajeetha Ravji, T.; Natarajaseenivasan, K.; Hema, T. Optimization and production of novel antimicrobial agents from sponge associated marine actinomycetes Nocardiopsis dassonvillei MAD08. Appl. Microbiol. Biotechnol. 2009, 83, 435–445. [Google Scholar] [CrossRef]
- Aruna, V. Antimicrobial activity of diethyl phthalate: An in silico approach. J. Adv. Sci. Res. 2020, 11, 158–165. [Google Scholar]
- Nafie, M.S.; Awad, N.M.; Tag, H.M.; Abd El-Salam, I.M.; Diab, M.K.; El-Shatoury, S.A. Micromonospora species from rarely-exploited Egyptian habitats: Chemical profile, antimicrobial, and antitumor activities through antioxidant property. Appl. Microbiol. Biotechnol. 2021, 105, 2427–2439. [Google Scholar] [CrossRef] [PubMed]
- Okudoh, V.I.; Wallis, F.M. Antimicrobial activity of rare actinomycetes isolated from natural habitats in KwaZulu-Natal, South Africa. S. Afr. J. Sci. 2007, 103, 216–222. [Google Scholar]
- Ambati, M.; Kumar, M.S. Microbial diversity in the Indian Ocean sediments: An insight into the distribution and associated factors. Curr. Microbiol. 2022, 79, 115. [Google Scholar] [CrossRef] [PubMed]
- DeCastro, M.-E.; Escuder-Rodríguez, J.-J.; Becerra, M.; Rodríguez-Belmonte, E.; González-Siso, M.-I. Comparative metagenomic analysis of two hot springs from Ourense (northwestern Spain) and others worldwide. Front. Microbiol. 2021, 12, 3534. [Google Scholar] [CrossRef] [PubMed]
- Meena, B.; Rajan, L.A.; Vinithkumar, N.V.; Kirubagaran, R. Novel marine actinobacteria from emerald Andaman & Nicobar Islands: A prospective source for industrial and pharmaceutical by-products. BMC Microbiol. 2013, 13, 145. [Google Scholar] [CrossRef]
- Arumugam, T.; Kumar, P.S.; Kameshwar, R.; Prapanchana, K. Screening of novel actinobacteria and characterization of the potential isolates from mangrove sediment of south coastal India. Microb. Pathog. 2017, 107, 225–233. [Google Scholar] [CrossRef] [PubMed]
- Irwin, J.A. Overview of extremophiles and their food and medical applications. In Physiological and Biotechnological Aspects of Extremophiles; Salwan, R., Sharma, V., Eds.; Academic Press: New York, NY, USA, 2020; pp. 65–87. [Google Scholar]
- Muduli, P.R.; Vinithkumar, N.; Begum, M.; Robin, R.; Vardhan, K.V.; Venkatesan, R.; Kirubagaran, R. Spatial variation of hydrochemical characteristics in and around port Blair Bay Andaman and Nicobar Islands, India. World Appl. Sci. J. 2011, 13, 564–571. [Google Scholar]
- Gupta, P.; Lal, B.; Nair, V. Solid CO2 storage by hydrate-based geo sequestration. In Nanotechnology for CO2 Utilization in Oilfield Applications; Sharma, T., Chaturvedi, K.R., Trivedi, J.J., Eds.; Elsevier: North Andover, MA, USA, 2022; pp. 251–273. [Google Scholar]
- Yano, Y.; Nakayama, A.; Ishihara, K.; Saito, H. Adaptive changes in membrane lipids of barophilic bacteria in response to changes in growth pressure. Appl. Environ. Microbiol. 1998, 64, 479–485. [Google Scholar] [CrossRef] [PubMed]
- Song, X.; Tao, B.; Guo, J.; Li, J.; Chen, G. Changes in the microbial community structure and soil chemical properties of vertisols under different cropping systems in northern China. Front. Environ. Sci. 2018, 6, 132. [Google Scholar] [CrossRef]
- Salaria, N.; Furhan, J. Antibacterial potential of actinomycetes from north-western Himalayas against pathogenic bacteria. Biol. Bull. 2021, 48, 281–289. [Google Scholar] [CrossRef]
- Tang, S.-K.; Tian, X.-P.; Zhi, X.-Y.; Cai, M.; Wu, J.-Y.; Yang, L.-L.; Xu, L.-H.; Li, W.-J. Haloactinospora alba gen. nov., sp. nov., a halophilic filamentous actinomycete of the family Nocardiopsaceae. Int. J. Syst. Evol. Microbiol. 2008, 58, 2075–2080. [Google Scholar] [CrossRef] [PubMed]
- De La Hoz-Romo, M.C.; Díaz, L.; Villamil, L. Marine actinobacteria a new source of antibacterial metabolites to treat acne vulgaris disease-a systematic literature review. Antibiotics 2022, 11, 965. [Google Scholar] [CrossRef] [PubMed]
- Okudoh, V.I. Isolation and Characterization of Antibiotic(s) Produced by Bacteria from KwaZulu-Natal Soils. Ph.D. Thesis, University of KwaZulu-Natal, Pietermaritzburg, South Africa, 2010. [Google Scholar]
- Mangamuri, U.; Muvva, V.; Poda, S.; Naragani, K.; Munaganti, R.K.; Chitturi, B.; Yenamandra, V. Bioactive metabolites produced by Streptomyces cheonanensis VUK-A from Coringa mangrove sediments: Isolation, structure elucidation and bioactivity. 3 Biotech. 2016, 6, 63. [Google Scholar] [CrossRef]
- Fabry, W.; Okemo, P.O.; Ansorg, R. Antibacterial activity of East African medicinal plants. J. Ethnopharmacol. 1998, 60, 79–84. [Google Scholar] [CrossRef]
- Mogana, R.; Adhikari, A.; Tzar, M.; Ramliza, R.; Wiart, C. Antibacterial activities of the extracts, fractions and isolated compounds from Canarium patentinervium Miq. against bacterial clinical isolates. BMC Complement. Med. Ther. 2020, 20, 55. [Google Scholar] [CrossRef] [PubMed]
- Aligiannis, N.; Kalpoutzakis, E.; Mitaku, S.; Chinou, I.B. Composition and antimicrobial activity of the essential oils of two Origanum species. J. Agric. Food Chem. 2001, 49, 4168–4170. [Google Scholar] [CrossRef] [PubMed]
- Nastasă, C.; Vodnar, D.C.; Ionuţ, I.; Stana, A.; Benedec, D.; Tamaian, R.; Oniga, O.; Tiperciuc, B. Antibacterial evaluation and virtual screening of new thiazolyl-triazole Schiff bases as potential DNA-gyrase inhibitors. Int. J. Mol. Sci. 2018, 19, 222. [Google Scholar] [CrossRef] [PubMed]
- Liu, S.; Chang, J.S.; Herberg, J.T.; Horng, M.-M.; Tomich, P.K.; Lin, A.H.; Marotti, K.R. Allosteric inhibition of Staphylococcus aureus D-alanine:D-alanine ligase revealed by crystallographic studies. Proc. Natl. Acad. Sci. USA 2006, 103, 15178–15183. [Google Scholar] [CrossRef] [PubMed]
- He, J.; Qiao, W.; An, Q.; Yang, T.; Luo, Y. Dihydrofolate reductase inhibitors for use as antimicrobial agents. Eur. J. Med. Chem. 2020, 195, 112268. [Google Scholar] [CrossRef] [PubMed]
- Hata, H.; Phuoc Tran, D.; Marzouk Sobeh, M.; Kitao, A. Binding free energy of protein/ligand complexes calculated using dissociation parallel cascade selection molecular dynamics and Markov state model. Biophys. Physicobiol. 2021, 18, 305–316. [Google Scholar] [CrossRef] [PubMed]
- Maliehe, T.S.; Selepe, T.N.; Mthembu, N.N.; Shandu, J.S. Antibacterial and anti-quorum sensing activities of Erianthemum dregeis leaf extract and molecular docking. Pharmacogn. J. 2023, 15, 279–285. [Google Scholar] [CrossRef]
- Chakraborty, C.; Mallick, B.; Sharma, A.R.; Sharma, G.; Jagga, S.; Doss, C.G.; Nam, J.S.; Lee, S.S. Micro-environmental signature of the interactions between druggable target protein, dipeptidyl peptidase-iv, and anti-diabetic drugs. Cell J. 2017, 19, 65–83. [Google Scholar] [CrossRef] [PubMed]
- Ashraf, Z.; Rafiq, M.; Seo, S.-Y.; Babar, M.M. Synthesis, kinetic mechanism and docking studies of vanillin derivatives as inhibitors of mushroom tyrosinase. Bioorg. Med. Chem. 2015, 23, 5870–5880. [Google Scholar] [CrossRef] [PubMed]
- Amer, H.H.; Eldrehmy, E.H.; Abdel-Hafez, S.M.; Alghamdi, Y.S.; Hassan, M.Y.; Alotaibi, S.H. Antibacterial and molecular docking studies of newly synthesized nucleosides and Schiff bases derived from sulfadimidines. Sci. Rep. 2021, 11, 17953. [Google Scholar] [CrossRef] [PubMed]

| Sample Code | Sample Description | L. monocytogenes Strains | STEC Strains | Resistance Phenotype for STEC Strains |
|---|---|---|---|---|
| KEmpBS18 | Chuck steak bone | — | KEmpBS18 * | A25-AP10-TE30-TS25 |
| KEmpBP21 | Beef burger | — | KEmpBP21 * | A25-AP10-TE30-TS25 |
| KVulFS71 | Brisket | — | KVulFS71 * | A25-AP10-CIP5-C30-FOX30-TE30 |
| KRbyGR83 | Biltong powder | — | KRbyGR83 * | A25-AP10-CIP5-C30-TS25 |
| KGEO151 | Ox intestines | — | KGEO151 * | A25-AP10-TE30-TS25 |
| KGEO161 | Ox liver | KGEO161 | KGEO161 | A25-AP10 |
| KmelDO248 | Cow heels | — | KmelDO248 * | A25-AP10-C30-TS25 |
| ILemanEO299 | Ox lungs | ILemanEO299 | ILemanEO299 * | A25-AP10-C30-TS25 |
| ILemanER317 | Burger | ILemanER317 | ILemanER317 | A25-AP10-FOX30 |
| ILemanAP345 | Mince | ILemanAP345 | — | |
| ILestanBR361 | Droewors | ILestanBR361 | — | |
| ILestanBR363 | Droewors | ILestanBR363 | — | |
| ILestanGP395 | Mince | ILestanGP395 | — | |
| ILestanGP400 | Burger patties | ILestanGP400 | — |
| Beaches | Physicochemical Parameters | ||||||
|---|---|---|---|---|---|---|---|
| pH ± SD | DO (%) ± SD | Specific Conductivity (mS/cm) ± SD | Total Dissolved Solids (g/L) ± SD | Salinity (PSU) ± SD | Temperature (°C) ± SD | Pressure (mmHg) ± SD | |
| Alkantstrand | 6.66 ± 0.22 ab | 30.22 ± 4.12 a | 49.14 ± 4.71 a | 24.57 ± 2.36 a | 32.39 ± 3.50 a | 24.17 ± 0.09 a | 749.79 ± 0.33 a |
| Blythedale | 6.86 ± 0.30 ab | 38.70 ± 8.15 a | 51.85 ± 0.39 a | 25.93 ± 0.19 a | 34.11 ± 0.28 a | 24.94 ± 0.44 a | 748.88 ± 0.10 b |
| Mthunzini | 6.79 ± 0.09 ab | 41.28 ± 5.53 a | 53.43 ± 0.22 a | 26.72 ± 0.11 a | 35.22 ± 0.16 a | 26.96 ± 0.09 b | 754.35 ± 0.16 c |
| Salt Rock | 6.73 ± 0.29 ab | 40.67 ± 1.72 a | 48.96 ± 5.25 a | 24.49 ± 2.63 a | 32.04 ± 3.70 a | 26.03 ± 0.01 c | 754.51 ± 0.09 c |
| Sodwana | 7.13 ± 0.05 a | 42.41 ± 5.50 a | 47.09 ± 10.09 a | 23.55 ± 5.04 a | 30.81 ± 7.14 a | 23.24 ± 0.49 d | 759.56 ± 0.49 d |
| Tinley Manor | 6.55 ± 0.13 b | 43.31 ± 4.31 a | 50.88 ± 2.16 a | 25.45 ± 1.08 a | 33.41 ± 1.60 a | 24.94 ± 0.27 a | 754.53 ± 0.09 c |
| STEC | Zones of Inhibition (mm) | |||||
|---|---|---|---|---|---|---|
| Actinomycetes | ||||||
| Primary Screening | Secondary Screening | |||||
| BLYST2SA3(i) | SOD(A)ST2SA2 | SOD(B)ST2SA2 | SRST1SA3 | TBST2SA1 | SOD(B)ST2SA2 | |
| KEmpBS18 | + | +++ | ++ | + | − | + |
| KEmpBP21 | ++ | ++ | ++ | + | + | + |
| KVulFS71 | ++ | − | − | ++ | − | + |
| KRbyGR83 | ++ | ++ | ++ | ++ | − | − |
| KGEO151 | + | ++ | ++ | + | + | − |
| KmelDO248 | + | +++ | + | ++ | + | + |
| ILemanEO299 | + | +++ | ++ | ++ | − | + |
| O157:H7 ATCC 43888 | +++ | +++ | +++ | +++ | + | + |
| L. monocytogenes | Zones of Inhibition (mm) | |||||
|---|---|---|---|---|---|---|
| Actinomycetes | ||||||
| Primary Screening | Secondary Screening | |||||
| BLYST2SA3(i) | SOD(A)ST2SA2 | SOD(B)ST2SA2 | SRST1SA3 | TBST2SA1 | SOD(B)ST2SA2 | |
| KGEO161 | +++ | +++ | +++ | +++ | +++ | + |
| ILemanAP345 | +++ | +++ | +++ | +++ | +++ | + |
| ILemanEO299 | +++ | +++ | +++ | +++ | +++ | + |
| ILemanER317 | +++ | +++ | +++ | +++ | +++ | + |
| ILestanBR361 | +++ | +++ | +++ | +++ | +++ | + |
| ILestanBR363 | +++ | +++ | +++ | +++ | +++ | + |
| ILestanGP395 | +++ | +++ | +++ | +++ | +++ | + |
| ILestanGP400 | +++ | +++ | +++ | +++ | +++ | + |
| Beach Name | Strain Number | GenBank Closest Known Species (Accession Number) | Identification |
|---|---|---|---|
| Blythedale | BLYST2SA3(i) | Streptomyces violaceoruber (CP0205701) Streptomyces californicus (CP070260.1) | Streptomyces sp. |
| Sodwana | SOD(A)ST2SA2 | Nocardiopsis dassonvillei (MF321787.1) Nocardiopsis dassonvillei (MH432693.1) Nocardiopsis dassonvillei subsp. albirubida (MG661744.1) Nocardiopsis dassonvillei (CP022434.1) Nocardiopsis dassonvillei (JN253591.1) | Nocardiopsis dassonvillei |
| Sodwana | SOD(B)ST2SA2 | Nocardiopsis dassonvillei (MT393632.1) Nocardiopsis dassonvillei (MH432693.1) Nocardiopsis dassonvillei subsp. albirubida (MG661744.1) Nocardiopsis dassonvillei (CP022434.1) Nocardiopsis dassonvillei subsp. albirubida (KC514117.1) Nocardiopsis dassonvillei (JN253591.1) Nocardiopsis dassonvillei (MF321787.1) | Nocardiopsis dassonvillei |
| Salt Rock | SRST1SA3 | Streptomyces sp. (MH910227.1) | Streptomyces sp. |
| Tinley Manor | TBST2SA1 | Streptomyces sp. (CP047147.1) Streptomyces albidoflavus (MF663704.1) | Streptomyces sp. |
| No. | Molecular Formula | Compound | Area % | Possible Biological Activity of the Identified Compound | Reference |
|---|---|---|---|---|---|
| 1. | C18H34O2 | 6-Octadecenoic acid, (Z) | 20.94 | Antimicrobial, anti-inflammatory, anti-androgenic, cancer-preventative, dermatitigenic hypochlolesterolemic, 5-alpha reductase inhibitor, and anemiagenic insectifuge | [53,54] |
| 2. | C18H36 | 1-Octadecene | 9.22 | Antimicrobial and anticancer activities | [55] |
| 3. | C18H33F3O2 | Trifluoroacetoxy hexadecane | 7.82 | Antifungal, anti-oxidant, and anticancer activity | [56,57,58] |
| 4. | C15H30O2 | Pentadecanoic acid | 5.86 | Anticancer, antibacterial, and antifungal activity | [59] |
| 5. | C12H14O4 | Diethyl phthalate | 3.43 | Antibacterial, antifungal, and anticancer activity | [60,61,62] |
| L. monocytogenes Strains | Zones of Inhibition (mm) | Chloroform Extract | Ciprofloxacin | |||
|---|---|---|---|---|---|---|
| Crude Extract (100 mg/mL) | Control (2 × 10−2 mg/mL) | MIC (mg/mL) | MBC (mg/mL) | MIC (mg/mL) | MBC (mg/mL) | |
| Chloroform | Ciprofloxacin | |||||
| KGEO161 | 15.33 ± 0.58 0 20.33 ± 0.58 14.67 ± 0.58 25.67 ± 1.15 28.67 ± 1.15 21.33 ± 0.58 23.00 ± 1.00 27.00 ± 0.40 | 24.7 ± 1.2 | 6.25 | > 25 | 2.5 × 10−3 | 2.5 × 10−3 |
| ILemanAP345 | 27.0 ± 2.7 | 6.25 | 25 | 1.6 × 10−4 | 1.25 × 10−3 | |
| ILemanEO299 | 40.3 ± 2.1 | 6.25 | 25 | 1.6 × 10−4 | 1.25 × 10−3 | |
| ILemanER317 | 24.0 ± 1.0 | 6.25 | 25 | 6.3 × 10−4 | 5 × 10−3 | |
| ILestanBR361 | 36.3 ± 1.2 | 6.25 | > 25 | 1.6 × 10−4 | 5 × 10−3 | |
| ILestanBR363 | 36.3 ± 1.5 | 6.25 | > 25 | 6.3 × 10−4 | 2.5 × 10−3 | |
| ILestanGP395 | 36.0 ± 5.3 | 6.25 | > 25 | 1.6 × 10−4 | 2.5 × 10−3 | |
| ILestanGP400 | 27.3 ± 1.2 | 6.25 | 25 | 6.3 × 10−4 | 1.25 × 10−3 | |
| ATCC 15313 | 42.0 ± 2.7 | 6.25 | 25 | 2.5 × 10−3 | 2.5 × 10−3 | |
| STEC Strains | Zones of Inhibition (mm) | Chloroform Extract | Ciprofloxacin | |||
|---|---|---|---|---|---|---|
| Crude Extract (100 mg/mL) | Control (2 × 10−2 mg/mL) | MIC (mg/mL) | MBC (mg/mL) | MIC (mg/mL) | MBC (mg/mL) | |
| Chloroform | Ciprofloxacin | |||||
| KEmpBS18 | 10.67 ± 0.58 | 46.33 ± 2.31 | 25 | 25 | 3.9 × 10−5 | 3.13 × 10−4 |
| KEmpBP21 | 10.33 ± 0.58 | 45.33 ± 0.58 | 25 | 25 | 3.9 × 10−5 | 7.8 × 10−5 |
| KVulFS71 | 11.67 ± 0.58 | 38 ± 2.65 | 3.13 | 6.25 | 3.9 × 10−5 | 7.8 × 10−5 |
| KRbyGR83 | 15.67 ± 1.15 | 47.33 ± 4.16 | 0.78 | 3.13 | 3.9 × 10−5 | 3.9 × 10−5 |
| KGEO151 | 0 | 42.33 ± 2.31 | — | — | 3.9 × 10−5 | 3.9 × 10−5 |
| KmelDO248 | 14.00 ± 1.00 | 48 ± 1.73 | 1.57 | 3.13 | 3.9 × 10−5 | 3.13 × 10−4 |
| ILemanEO299 | 14.33 ± 0.58 | 50 ± 5.57 | 25 | >25 | 3.9 × 10−5 | 7.8 × 10−5 |
| O157:H7 ATCC 43888 | 16.33 ± 1.15 | 40.67 ± 1.15 | 1.57 | 3.13 | 3.9 × 10−5 | 7.8 × 10−5 |
| Ligands | Receptors | Binding Energy Scores (Kcal/mol) |
|---|---|---|
| Pentadecanoic acid | DDI | −5.0 |
| DNA gyrase B | −5.2 | |
| Dihydrofolate reductase | −6.3 | |
| Diethyl phthalate | DDI | −5.8 |
| DNA gyrase B | −6.0 | |
| Dihydrofolate reductase | −7.2 | |
| 1-Octadecene | DDI | −4.9 |
| DNA gyrase B | −4.8 | |
| Dihydrofolate reductase | −6.4 | |
| Ciprofloxacin (control) | DDI | −7.5 |
| DNA gyrase B | −7.6 | |
| Dihydrofolate reductase | −9.6 |
Disclaimer/Publisher’s Note: The statements, opinions and data contained in all publications are solely those of the individual author(s) and contributor(s) and not of MDPI and/or the editor(s). MDPI and/or the editor(s) disclaim responsibility for any injury to people or property resulting from any ideas, methods, instructions or products referred to in the content. |
© 2023 by the authors. Licensee MDPI, Basel, Switzerland. This article is an open access article distributed under the terms and conditions of the Creative Commons Attribution (CC BY) license (https://creativecommons.org/licenses/by/4.0/).
Share and Cite
Ngema, S.S.; Khumalo, S.H.; Ojo, M.C.; Pooe, O.J.; Malilehe, T.S.; Basson, A.K.; Madoroba, E. Evaluation of Antimicrobial Activity by Marine Nocardiopsis dassonvillei against Foodborne Listeria monocytogenes and Shiga Toxin-Producing Escherichia coli. Microorganisms 2023, 11, 2539. https://doi.org/10.3390/microorganisms11102539
Ngema SS, Khumalo SH, Ojo MC, Pooe OJ, Malilehe TS, Basson AK, Madoroba E. Evaluation of Antimicrobial Activity by Marine Nocardiopsis dassonvillei against Foodborne Listeria monocytogenes and Shiga Toxin-Producing Escherichia coli. Microorganisms. 2023; 11(10):2539. https://doi.org/10.3390/microorganisms11102539
Chicago/Turabian StyleNgema, Siyanda S., Solomuzi H. Khumalo, Michael C. Ojo, Ofentse J. Pooe, Tsolanku S. Malilehe, Albertus K. Basson, and Evelyn Madoroba. 2023. "Evaluation of Antimicrobial Activity by Marine Nocardiopsis dassonvillei against Foodborne Listeria monocytogenes and Shiga Toxin-Producing Escherichia coli" Microorganisms 11, no. 10: 2539. https://doi.org/10.3390/microorganisms11102539
APA StyleNgema, S. S., Khumalo, S. H., Ojo, M. C., Pooe, O. J., Malilehe, T. S., Basson, A. K., & Madoroba, E. (2023). Evaluation of Antimicrobial Activity by Marine Nocardiopsis dassonvillei against Foodborne Listeria monocytogenes and Shiga Toxin-Producing Escherichia coli. Microorganisms, 11(10), 2539. https://doi.org/10.3390/microorganisms11102539

